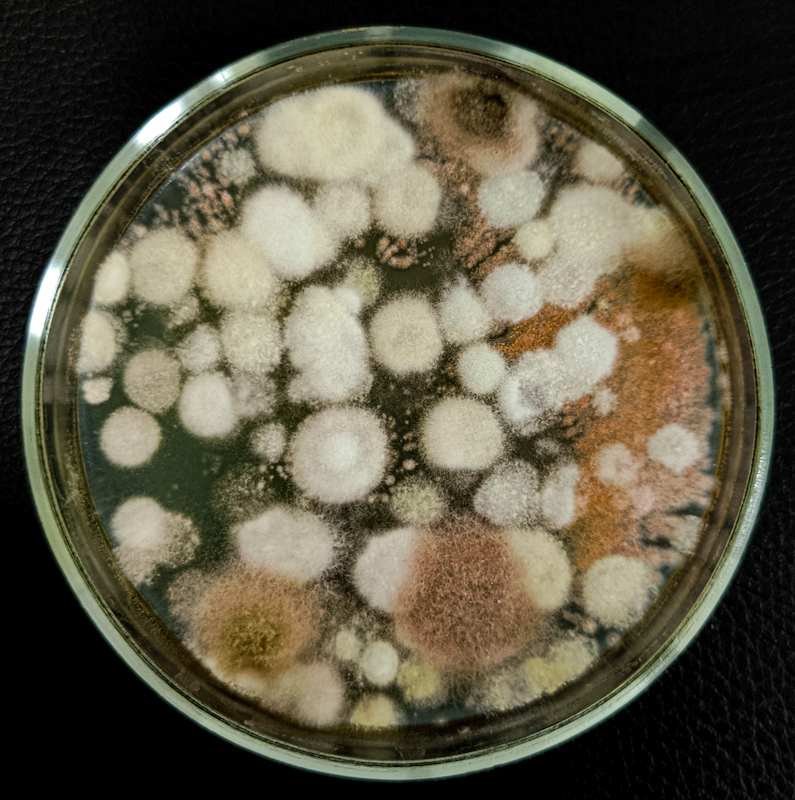
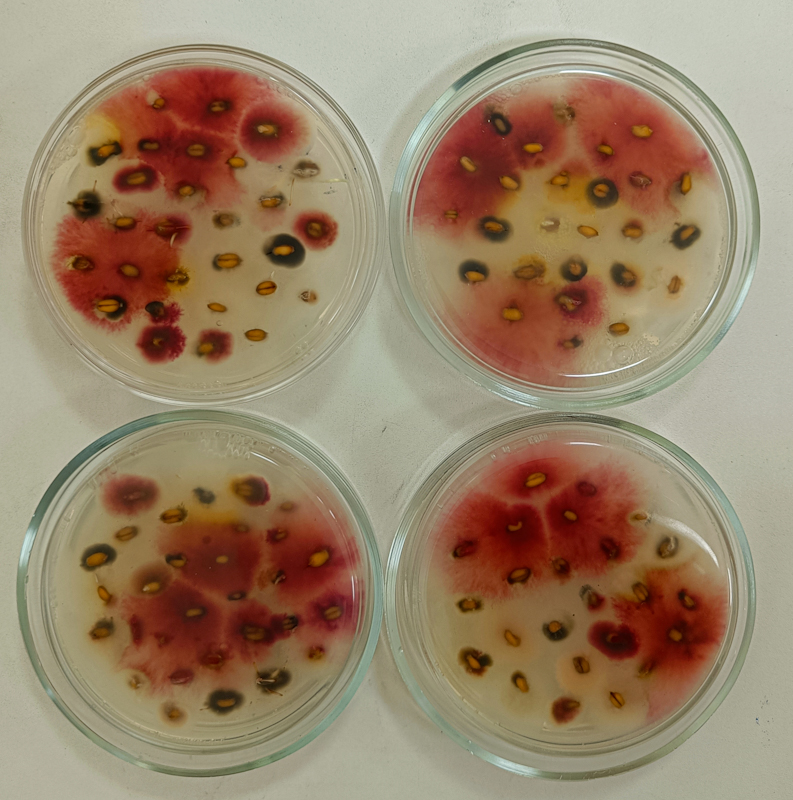
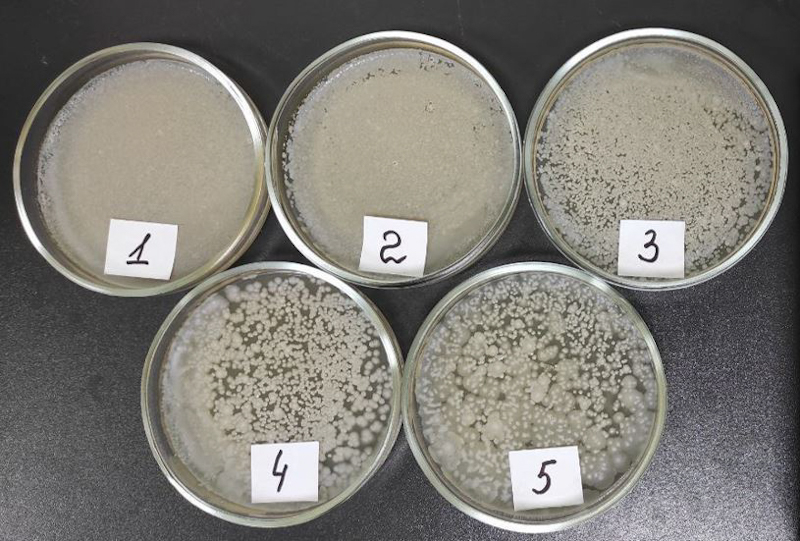

Як власна мікробіологічна лабораторія допомагає «Контінентал» бути на крок попереду
- Деталі
- Статті
- 8940
Пошук найбільш економічно обґрунтованих рішень — незмінна потреба будь-якого бізнесу. У кризових умовах вона тільки загострюється. Однак окрім звичних викликів аграрна галузь постійно натрапляє на все нові: кліматичні зміни, загроза деградації ґрунтів, необхідність оптимізації й ощадного використання ресурсів, підвищення ефективності виробництва та непрогнозовані зміни ринку, реагувати на які треба гнучко й оперативно
Щоб аналізувати стан ґрунтів, якість насіннєвого матеріалу та біопрепаратів, агрохолдинги замовляють дослідження в сертифікованих незалежних лабораторій або спираються на результати дослідів, надані виробниками насіння та ЗЗР, здійснені на базі їхніх науково-дослідних центрів. І в першому, і в другому випадках є свої мінуси. Якщо в роботі з лабораторіями — це терміни очікування і висока ціна послуг, то у співпраці з агрохімічними або селекційними компаніями — питання вірогідної упередженості результатів. Адже виробники зацікавлені насамперед просувати власний продукт — показати ефективність своїх препаратів і стійкість гібридів до хвороб. Однак верифікувати надані показники у цьому разі вкрай складно.
З’являються поодинокі випадки, коли агрокомпанії намагаються розвивати альтернативу на базі власних потужностей — зокрема напрацьовувати й тестувати біопрепарати. Компанія «Контінентал Фармерз Груп» обрала стратегічний шлях, що допомагає поступово, але впевнено долати згадані виклики й швидше, і дешевше: уже другий сезон тут працюють власні лабораторії — для визначення якості насіння та мікробіологічна. Як вони функціонують та в чому їх переваги? — досвідом поділилися працівники управління розвитку та інновацій «Контінентал Фармерз Груп» Дмитро Зайцев та Олександр Акулов.
Розвиток заради результативності
Важливість наукового обґрунтування процесів виробництва в «Контінентал» зрозуміли давно. Перші кроки до точного землеробства компанія зробила, впроваджуючи новітні технологічні рішення з автоматизації та навігації й була одним із трендсеттерів галузі в цьому напрямі. Однак тісніша й продуктивніша співпраця з науковцями розпочалася кілька років тому.
Так, із 2020 року в «Контінентал» функціонує потужний науково-дослідний відділ, діяльність якого спрямовано на пошук найкращих економічно обґрунтованих агрономічних рішень для підвищення ефективності виробництва. Спеціалісти цього відділу закладають аграрні досліди на двох науково-дослідних пунктах. А також забезпечують науковий супровід виробничих дослідів, закладених безпосередньо в умовах агровиробництва.
З появою лабораторій вони поєднали дослідницьку роботу в полі та стаціонарних контрольованих умовах, підвищуючи не лише якість здійснюваних досліджень, а й довіру до них. Зокрема, з’явилася можливість зіставлення результатів, отриманих у різних умовах. Спираючись тільки на лабораторні дані, технологічні карти не корегують — обов’язковою є верифікація отриманого результату в полі. До того ж попередній лабораторний скринінг допомагає мінімізувати кількість варіантів, які згодом тестуватимуть на дослідних полях, і концентруватись на тих, що найкраще показали себе в лабораторії.
Олександр Акулов, завідувач кафедри мікології та фітоімунології ХНУ імені В. Н. Каразіна, співпрацює з «Контінентал» протягом багатьох років. Він став ініціатором створення в компанії власної лабораторії. Науковець розповідає:
— Деяким проблемам ми можемо запобігти. Наприклад, аналіз якості насіння дає змогу правильно підібрати протруйник. Проаналізувавши ґрунт і сівозміну, прогнозуємо потенціал розвитку хвороб на певному полі й модифікуємо системи захисту. Однак трапляються ситуації, коли потрібно швидко визначити, яка саме хвороба розвивається на полі, які препарати проти неї ефективні, а які — ні. Маючи власну лабораторію, ми можемо реагувати оперативніше. Бо як тільки десь виникає проблема, нам одразу надсилають зразки, ми в цей же день проводимо дослідження і часто вже через день-два маємо результати. Налагоджена комунікація дозволяє в режимі реального часу, не чекаючи жодних звітів, передавати найцікавішу і найважливішу інформацію в агрономічну службу, а їм — одразу ухвалювати рішення.
Звісно, низку досліджень компанія й далі замовляє назовні. Йдеться про ті, для яких потрібне дуже спеціалізоване обладнання — наприклад, агрохімічний аналіз ґрунту або моніторинг умісту залишків пестицидів чи мікотоксинів на хроматографі. Проте значну частину необхідних досліджень спеціалісти «Контінентал» виконують власними силами, до того ж постійно і регулярно, в режимі моніторингу. Зокрема, це: визначення грибних і бактеріальних хвороб рослин, якості насіннєвого матеріалу, якості біопрепаратів, аналіз ґрунту на активність мікробіоти, целюлозолітичну активність деструкторів, мікроскопія, визначення чутливості культур-патогенів до пестицидів. До слова, співробітники виростили власну колекцію місцевих ізолятів патогенів із полів компанії й у зимовий період планують тестувати їх чутливість до препаратів, які застосовують у компанії. Всі ці досліди допомагають поглибити диверсифікацію закупівель і обрати найкращі системи захисту для культур на різних кластерах. Також наявність лабораторії дає змогу гнучко змінювати план випробувань, коли через погодні умови відсутній або, навпаки, посилений тиск хвороб на виробничих і дослідних полях.

Ключ до успіху — в людях
Для запуску лабораторії «Контінентал» знадобився лише сезон — від появи задуму навесні торік до його втілення восени. Будувати з нуля нічого не довелося, бо на активах компанії знайшлося належне приміщення поблизу науково-дослідного пункту в м. Хоросткові, що зручно для агрономів-дослідників із погляду логістики. Його пристосували до потреб лабораторії, закупили обладнання та меблі, і ось уже рік лабораторія повноцінно функціонує.
За словами Дмитра Зайцева, начальника управління розвитку та інновацій «Контінентал Фармерз Груп», найскладніше в організації цього процесу — не пошук приміщення чи закупівля обладнання, а підбір людей, які мають належну кваліфікацію й зуміють суміщати агрономічні та лабораторні навички.

— Як правило, є агрономи, які добре знаються на тому, що відбувається в полі, і є лабораторні працівники, які в білому халаті працюють у лабораторії. Кожен із цих напрямів роботи має свою специфіку. Та ми не розподіляємо людей на «лабораторних» і «польових», у нас працюють агрономи, які паралельно є дослідниками. З одного боку, від них потрібне знання технологій вирощування наших основних культур, але так само важливе розуміння, які лабораторні методи треба застосувати, щоб посилити польову складову. Залежно від ситуації, потреб, погодних умов і, врешті-решт, від пори року вони концентруються на різних завданнях. Наприклад, улітку можуть більше часу й уваги приділяти роботі в полі, а взимку — лабораторним дослідам.
Дехто з агрономів-дослідників, залучених у діяльності лабораторії, має агрономічну освіту, дехто — біологічну. Є такі, хто зовсім недавно успішно закінчив піврічне стажування за нашою програмою «Майбутнє Контінентал» і лишилися на роботі в компанії. Окрім того, ми не припиняємо співпрацювати з науковими закладами, а багато хто вирішив здобувати додаткову вищу освіту, щоб поглиблювати свої знання і навички. Вважаю, що цей напрям у «Контінентал» має відмінні перспективи, враховуючи, що вдалося підібрати такий штат і професійно розвивати молодих спеціалістів. Це доволі унікальний для України досвід.
________________________
ДО РЕЧІ
За програмою «Майбутнє Контінентал» уже стажувалося чотири хвилі студентів старших курсів і випускників аграрних спеціальностей. У рамках цієї програми молоді спеціалісти отримують унікальну можливість здобути практичний досвід в умовах агровиробництва на посадах агронома та механіка й перейняти знання від найкращих експертів «Контінентал Фармерз Груп». Стажування оплачуване, а компанія регулярно проводить набір на нові хвилі програми. Дізнатися більше можна на офіційному сайті.
________________________
Запуск роботи мікробіологічної лабораторії в «Контінентал» називають тільки першим кроком. Компанія планує активно розвивати напрям і будувати власну молекулярно-генетичну лабораторію на базі наявної.

— Щороку для нас велику проблему становить, скажімо, склеротинія, яка спричиняє склеротиніоз, — розповідає Олександр Акулов. — Тож ми виростили в лабораторії колекцію ізолятів склеротинії з різних культур у розрізі наших кластерів і блоків. І тепер можемо тестувати чутливість саме нашої склеротинії з конкретних локацій до певних діючих речовин або біопрепаратів. Проте деякі види фітопатогенів складно, а то й неможливо виростити на штучних середовищах — це, наприклад, борошниста роса, іржа. Важливою є рання діагностика хвороби; нерідко в ураженій рослині може бути не один, а 2-3-4 види мікроорганізмів, які розвиваються спільно й заважають ідентифікувати основну причину хвороби. Чимало видів мікроорганізмів складно ідентифікувати на рівні виду класичними методами. Зважаючи на все це, найнадійнішим і найшвидшим методом ідентифікації, за якого мінімізується людський чинник, все-таки є генетичний аналіз. Можна взяти безпосередньо листки з ознаками хвороби, видалити ДНК, підтвердити наявність або відсутність патогену. Також можна за певними генетичними мутаціями з’ясувати, чи чутливий патоген до певної речовини. Метод дозволяє визначити, чи прижився інокулянт тощо. Генетичний аналіз є набагато точнішим. Окрім того, вирощування культури триває певний час, відповідно, результат можна отримати за 7–10 днів. А іноді він може бути потрібен «на завтра», тому ми вирішили не зупинятися на досягнутому і будувати в себе молекулярно-генетичну лабораторію. Увесь світ уже давно не сприймає генетичний аналіз як якусь екзотичну дивину, як щось дуже дороге, як забавку для обраних. Це давно стало загальнодоступним інструментом. Тож якщо ми хочемо крокувати в ногу з часом і працювати ефективно, то нам треба рухатися в цьому напрямі. Мікробіологія — тільки перший логічний крок до генетики. Цього кроку нам дуже бракувало, щоб розвиватися далі.


